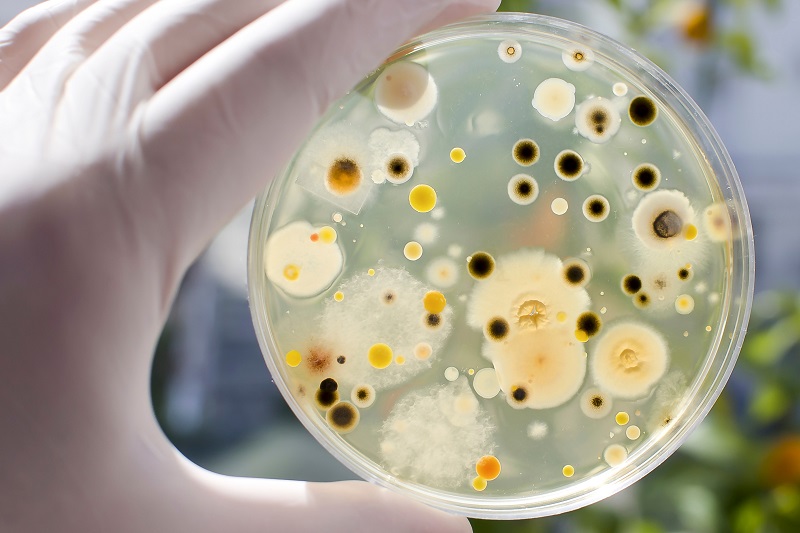
Microbiological Testing

Leading Environmental Testing Services for a Sustainable Future
Environmental Services at Eurofins
At Eurofins Environmental Services, we offer a comprehensive range of water, air and soil analysis services tailored to meet your environmental, health and safety legislation compliance needs.
Water Testing Services
Our water testing encompasses the full spectrum of chemical and microbiological analysis for both natural and built environments. We support our clients in demonstrating compliance with environmental, health, and safety legislation across various water systems, including:
- Ground water
- Surface water
- Drinking Water
- Waste water (discharge consent licenses)
- Process water (cooling towers, domestic, ingress, primary hot & chilled water systems)
- Recreational water
Our clients consistently return to us, with the majority of our work coming from repeat business—a testament to the trust we’ve built over time.
Our Strengths 
- Regulatory Expertise: We deeply understand the regulatory and legislative pressures companies face. Our expertise ensures that you remain compliant with current standards.
- Accredited Laboratories: Through our network of ISO17025 accredited laboratories, we deliver accurate and reliable results.
- Specialized Team: Our team includes highly trained analysts, technical experts, and sampling specialists, ensuring your tests are conducted with precision and speed.
Whether you're looking to maintain compliance, improve operational efficiency, or safeguard the environment, Eurofins is here to provide the reliable and timely results you need.
Please click the INAB Certificate for our scope of accreditations or read more .
Our Services
Why Choose Eurofins Environmental Testing Ireland
Unmatched Expertise
With decades of experience, Eurofins leads in providing reliable and accurate environmental testing, using innovative methods to meet the highest safety and compliance standards.
Comprehensive Testing Solutions
We offer a full range of services, including water, soil, air quality testing, solvent analysis, and PFAS detection, catering to industries like pharmaceuticals, chemicals, and automotive.
Advanced Technology
Utilizing cutting-edge techniques like GC-MS and ICP-MS, we deliver precise results with the latest lab technologies to meet your testing needs.
Fast Turnaround
Our efficient processes and quick turnaround times ensure timely, compliant results to keep your projects on track.
Sustainability Focus
Environmental protection is core to our mission, helping clients reduce waste, minimize impact, and meet evolving regulations.
Accreditation & Compliance
Our ISO 17025 accredited labs ensure results meet national and international regulatory standards with top-tier quality control.
Tailored Support
We provide customized testing solutions and personalized support, working closely with you to meet your specific needs.
Global Reach, Local Expertise
Backed by a global network and local knowledge of Irish regulations, Eurofins offers broad environmental testing with regional expertise.